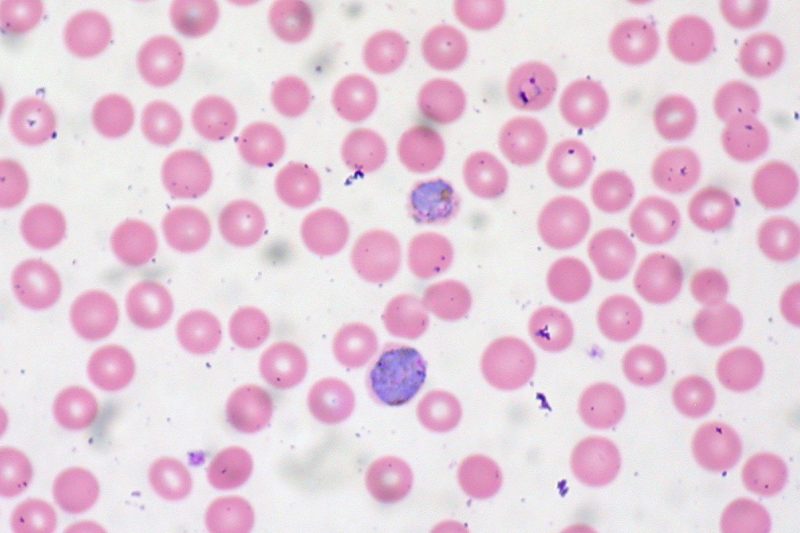

The most devastating diseases in history
Humankind has a bigger threat than famine, terrorism, asteroid impact, or wars. The greatest existential danger it faces is the risk posed to it by disease. Throughout history, nothing has taken as many lives or threatened humanity as much as the plagues that have devastated our planet many times.
In this article, we’ll discuss a few of the deadliest plagues in human history. After reading it, you’ll probably realize that disease is a significant threat with tragic repercussions, and we always have to be ready for the next pandemic.
The Black Death

This disease, also known as the Bubonic Plague, is one of the most notorious in history, and it’s found in almost every history textbook. The reason why this plague is so infamous is that it killed almost half of Europe’s population in the span of only four years. Between 1347 to 1351, 30-60% of Europe’s 450 million people died from this disease.
It was probably caused by fleas carried by rodents which came to Europe from Asia via the Silk Road. The plague caused massive religious and political upheavals throughout Europe. There are small pockets of the disease at times to this day in some isolated areas in Eastern Hemisphere.
The plague of Justinian
Ultimately claiming the lives of over 25 million people in 541 A.D., this plague is named after the ruling Roman Emperor of the time, and he himself contracted the disease. It’s known as one of the greatest disasters in the history of the Roman Empire.

The plague probably began with rats traveling via boats to the Eastern Roman Empire from Egypt. It killed over 25% of all people who lived on the eastern side of the Mediterranean.
Tuberculosis
The first records of Tuberculosis date back in the days of Ancient Egypt, and it continues to claim millions of lives. It’s caused by an airborne bacteria that attacks the lungs. The attacks lead to unbearable chest pain and extreme coughing.

During the 19th Century, tuberculosis swept across Europe and killed 25% of people who lived there. The disease still exists today, claiming almost two million lives every year.
Smallpox

This epidemic originally traveled from Europe to North America in the 1600s. The disease started spreading in 1633 across the east coast and into the Northeast. It killed over 70% of the Native American tribes in the area. The case of 1633 was the worst in history, even though the disease had been around for many years before that.
Malaria
This disease is one of the earliest ever recorded. The first record of it dates back over four thousand years. Caused by mosquito bite, today half a billion people are diagnosed with it annually. Most of the cases are in Arica.
Fortunately, not as many people are killed by this disease today. But, during World War II, over one hundred thousand U.S. troops were killed by malaria, which shows the devastating nature of this disease.
Spanish flu
The Spanish Flu pandemic first began in Kansas in 1918 and spread very quickly to many countries in the world. The disease claimed the lives of around fifty million people, including many soldiers fighting in World War I.
It ultimately ended in 1920, and it’s still a mystery how and why it ended so quickly. The short existence of the disease doesn’t negate the fact that it was one of the most fatal in human history.
Cholera
This disease was discovered in the 19th Century in India but quickly started spreading throughout the world. It’s caused and spread by the contamination of water and food. Violent vomiting, dehydration, and cramping are a few of the symptoms of the disease.

If the victim doesn’t get enough water, it can even lead to death. Each year, over one hundred thousand people are killed by cholera, and almost five million people are diagnosed. The most recent record of a cholera outbreak was in 2010, in Haiti. The disease killed seven thousand people, and it’s still being fought.
These were just a few of the deadly diseases that have devastated people throughout our history. Unfortunately, you can never be certain that you won’t ever fall victim to one of them. We can easily say that diseases are the biggest killers, and they are certainly a real threat to human kind.

Though you can easily catch a deadly disease, you should, of course, try to prevent such an event occurring. Make sure you adopt healthy personal hygiene and sanitation standards in your everyday life. It’s also crucial to know how to use first aid and medical equipment. Stay safe.
If you have any comments then please drop us a message on our Outdoor Revival Facebook page
If you have a good story to tell or blog let us know about it on our FB page, we’re also happy for article or review submissions, we’d love to hear from you.
We live in a beautiful world, get out there and enjoy it.
Outdoor Revival – Reconnecting us all with the Outdoors.